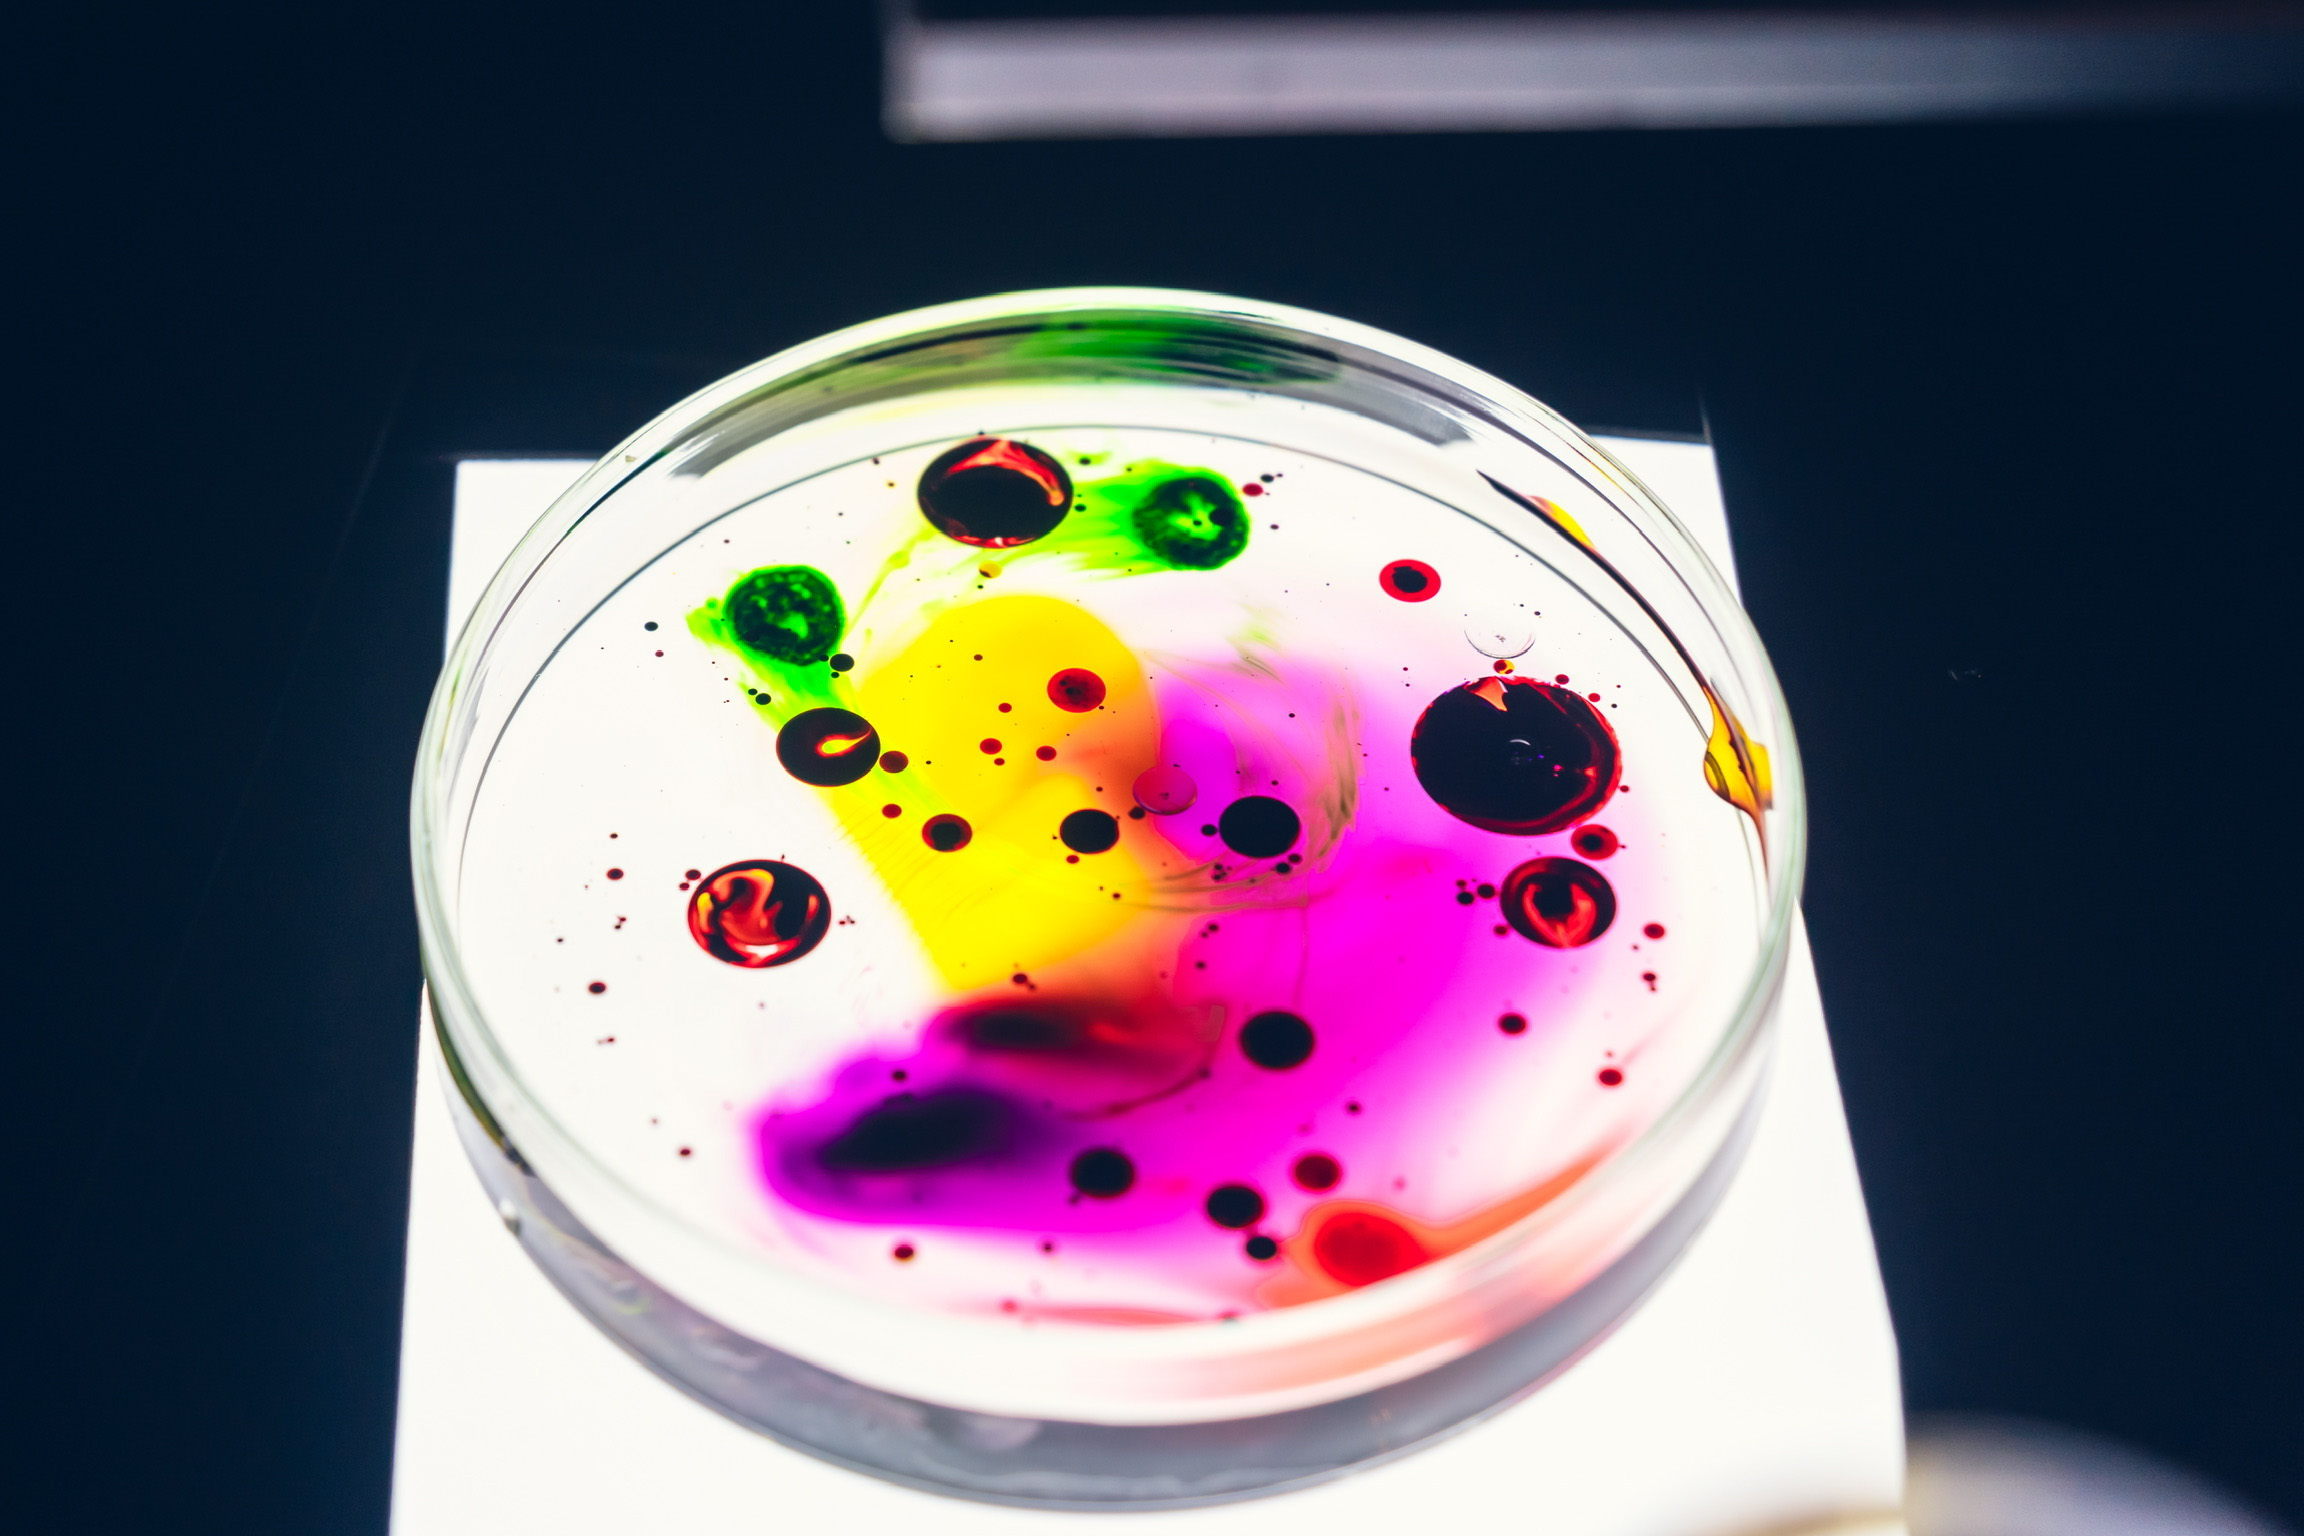

Querico @Enter Iñigo Vontier
Another endless night of psychotropical boogie. We featured 2 international artists IÑIGO VONTIER & ALDONNA. From Mexican inspired psychedelic house and Detroit techno grooves to euphoric soundscapes from Australia, expect nothing but RICA MÚSICA !
Standing in the front line of local Japanese talent, GROUND joins the line up. With strong presence in the Osaka underground culture, he’s also known for his producing and collaborations with renowned artists such as Nicolas Cruz. British-Italian AL JONES brings his heat from his globetrotting lifestyle. And finally FU our resident, making her way through the scene with her eclectic selection of deep house.

No items found.
Other Past Events
Querico - AGAPARADISE in Hong Kong
March 7, 2026
Venue:
Hidden & private venue by the beach (HK Island)
Location:
HK island

Querico - Hakuba Takeover @CONCRETE Hakuba, Nagano
February 14, 2026
Venue:
CONCRETE
Location:
Hakuba

